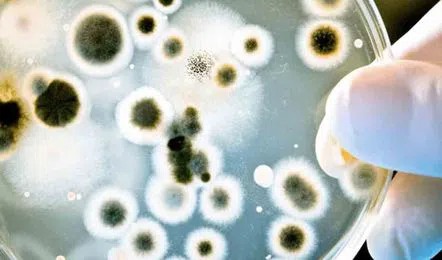

భారత్ న్యూస్ ఢిల్లీ…..ఢిల్లీ గాలిలో యాంటీ బయాటిక్ కి లొంగని బ్యాక్టీరియా… జనానికి శ్వాస సమస్యలు
దేశ రాజధాని నగరం ఢిల్లీలో శీతాకాలంలో గాలి కాలుష్యం వేధిస్తున్నది.
దీంతోపాటు సూక్ష్మజీవ నాశక ఔషధాలకు లొంగకుండా, మనుగడ సాగించే సత్తాగల (యాంటీబయాటిక్-రెసిస్టెంట్) బ్యాక్టీరియా చెప్పుకోదగ్గ స్థాయిలో పెరిగింది.
ముఖ్యంగా స్టఫిలోకోక్సి అనే బ్యాక్టీరియా వృద్ధి చెందింది. జవహర్లాల్ నెహ్రూ విశ్వవిద్యాలయం పరిశోధకులు ఈ నగరంలోని వివిధ ప్రాంతాలు, మురికివాడల్లో అధ్యయనం చేసి, ఈ వివరాలను వెల్లడించారు.